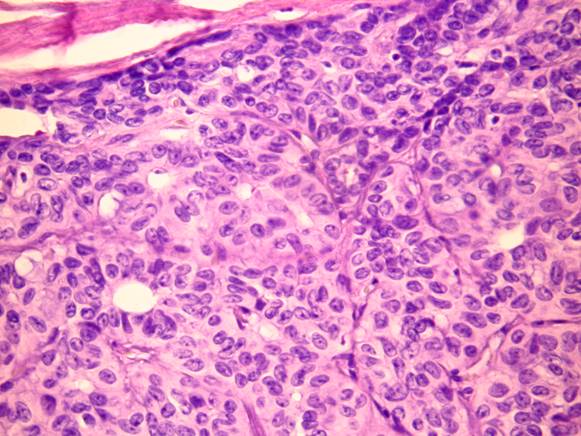

Ένας στους δέκα Έλληνες πάσχει από κάποιο νόσημα γνωστό και ως αυτοάνοσο, λ.χ. διαβήτη, ρευματοειδή αρθρίτιδα, ψωρίαση και όχι μόνο. Πρόκειται για…αυτοκαταστροφικά νοσήματα, καθώς το σώμα μας επιτίθεται και καταστρέφει τα δικά του κύτταρα και όργανα χωρίς προφανή αιτία. Είναι, μάλιστα, τέτοια η έξαρση των αυτοάνοσων νοσημάτων που προ πολλού έχουν ξεπεράσει αριθμητικά τα περιστατικά καρδιακών νοσημάτων και καρκίνου.
Ποια είναι τα κύρια αυτοάνοσα νοσήματα
Ασθένειες όπως η σκλήρυνση κατά πλάκας, ο διαβήτης, η ρευματοειδής αρθρίτιδα,η θυρεοειδίτιδα Hashimoto, η ψωρίαση, η ελκώδης κολίτιδα, η νόσος του Crohn, ο ευθυματώδης λύκος, οι δερματίτιδες, η μυασθένεια και η νόσος Αλτσχάιμερ είναι τα κύρια αυτοάνοσα νοσήματα και αυξάνονται δραματικά τα τελευταία 15 χρόνια. Καθώς μάλιστα είναι χρόνια νοσήματα, το άτομο που πάσχει πρέπει να λαμβάνει πολύπλοκα φαρμακευτικά σχήματα για την υπόλοιπη ζωή του.
Τι πυροδοτεί τα αυτοάνοσα νοσήματα
Όπως παρατηρεί ο Dr. Δημήτρης Τσουκαλάς, ειδικός στα Χρόνια Νοσήματα και στις Μεταβολικές Διαταραχές, «σύμφωνα με νέες μελέτες, όσο υψηλότερο είναι το βιωτικό επίπεδο τόσο μεγαλύτερη είναι η επίπτωση των αυτοάνοσων νοσημάτων. Αυτό είναι το τίμημα που πληρώνουμε για έναν τρόπο ζωής που συνεχώς απομακρύνεται από το φυσιολογικό. Για να κατανοήσουμε, όμως, τον μηχανισμό «γέννησης» ενός αυτοάνοσου νοσήματος, πρέπει να εξετάσουμε το θέμα εκεί που προκύπτει: σε επίπεδο κυττάρων».
Το σώμα μας επιτίθεται στα νέα… μεταλλαγμένα μας κύτταρα
Πρόσφατες έρευνες αναδεικνύουν ότι η αλλαγή της βιοχημικής σύστασης του εσωτερικού των κυττάρων συνοδεύεται με αλλαγή της μεμβράνης και της εξωτερικής εικόνας του κυττάρου. Ως αποτέλεσμα των παραπάνω, το σώμα δεν αναγνωρίζει πλέον αυτά τα κύτταρα ως δικά του και τους επιτίθεται! Σε πολλές περιπτώσεις, μάλιστα, το σώμα επιτίθεται σε πάνω από ένα όργανα ή συστήματα( συνύπαρξη πολλαπλών αυτοάνοσων νοσημάτων).
Γιατί, όμως, άλλαξε η δομή των κυττάρων μας
Η λειτουργία των κυττάρων σχετίζεται, κατ΄ αρχήν, με τη διατροφή μας. Με δεδομένες τις αλλαγές των διατροφικών μοντέλων τα τελευταία 50 χρόνια, τα κύτταρά μας δεν προσλαμβάνουν τα απαραίτητα μεταλλικά στοιχεία, αμινοξέα, πρωτεΐνες, βιταμίνες, ένζυμα, λίπη και υδατάνθρακες. Τα κύτταρα μας λοιπόν, δεν προσλαμβάνουν από τα σύγχρονα διατροφικά προϊόντα τα στοιχεία που χρειάζονται για να λειτουργήσουν. Σιγά-σιγά δημιουργούνται ελλείψεις σε κυτταρικό και μοριακό επίπεδο.
«Το πρόβλημα όμως δεν σταματάει εδώ. Πέρα από τις ελλείψεις που παρουσιάζουν τα κύτταρα μας, επιβαρύνονται και με τοξικές ουσίες, παρατηρεί ο κ. Τσουκαλάς. Βαρέα μέταλλα, βιομηχανικά χημικά, φάρμακα και άλλες ενώσεις ξένες προς τη ζωή εισέρχονται σε κάθε κύτταρο μας.
Το στρες «φουντώνει» τα αυτοάνοσα νοσήματα
Πίσω από κάθε αυτοάνοσο νόσημα κρύβεια και κάποιος στρεσογόνος παράγοντας. Σχεδόν πάντοτε, τα αυτοάνοσα νοσήματα συνοδεύονται από έντονες αλλαγές στη διάθεση που ανατροφοδοτούν τη νόσο και επιδεινώνουν την εικόνα της. Η βιοχημική αλλοίωση και το στρες που συνοδεύει το σύγχρονο περιβάλλον είναι οι βασικοί υπαίτιοι πίσω από την έκρηξη των αυτοάνοσων νοσημάτων.
Πηγή: healthpress.gr